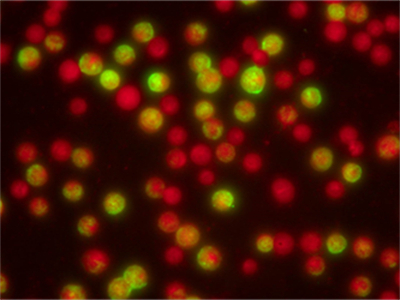
呼吸道病毒九联检

蓝色激发光组,通过推拉滑块选择合适的激发光组,进行荧光观察或切换明场观察,广泛应用于呼吸道疾病、生殖道疾病、结核杆菌、自身免疫性疾病等领域的荧光检测。通用型荧光模块,方便显微镜的升级改造,不仅可以匹配我司显微镜,也可以灵活地匹配其他国产和进口品牌采用无限远光路系统的显微镜,例如:CX23/CX31/E100/DM500/Primo Star等,升级为荧光观察显微镜。(详情可咨询我司)
正置荧光模块(蓝色)B-LED-MH(RB)通用型荧光模块,方便显微镜的升级改造,不仅可以匹配我司显微镜,也可以灵活地匹配其他国产和进口品牌采用无限远光路系统的显微镜,例如:CX23/CX31/E100/DM500/Primo Star等,升级为荧光观察显微镜。(详情可咨询我司)
光源 | 可调节LED |
使用寿命 | >20000h |
光线调节范围 | 0-100%线性调节 |
观察方式 | 明场/荧光 |
荧光通道数 | 单通道 |
激发滤色片 | 470/30nm |
分光滤色片 | 505nm |
发射滤色片 | 515nmLP |
LED中心波长 | 475nm |
切换方式 | 推拉 |

热线020-87096762

致电13418179239